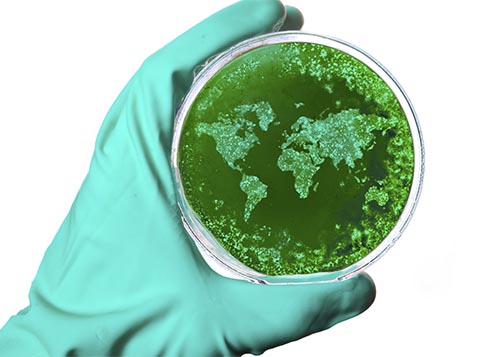

Health

Demanding data for better healthcare
A major focus for medical technology is data sharing, with experts from across the healthcare sector looking to connect.

Morphine provokes pain
An international study into morphine has found it may contribute to chronic pain, prompting the development of new drugs to reduce its long-term effects.

Brain-powered bionic spine
A thought-powered device that will enable paralysed people to walk is on the path to commercialisation, thanks to Australian neurologist Dr. Thomas Oxley.

A “vinnovative” solution
An innovative bottle closure with the potential to significantly reduce wine allergies is being developed in Australia’s most famous wine region.

Thrill of discovery
Biochemist and passionate supporter of gender equality in science, Marilyn Anderson, challenges the norm.

Wearable diabetes patch
Scientists are working to take the sting out of controlling diabetes.

Microcapsules for type-1 diabetes
Curtin University designs unique microcapsules for people with type-1 diabetes.

A 3D printed smile
Griffith University uses 3D tissue engineering to revolutionise dental disease.

Biobank speeds autism diagnosis
Australia’s first ever Biobank will speed up and improve autism diagnosis in children.

Apps for youth mental health
New online tools are helping young people to take control of their own mental wellbeing.

Smart Contact Lens
New light-manipulating nanotechnology may soon be used to make smart contact lenses.

Smart ASD detection tool
La Trobe University has launched a free app that can identify autism earlier and more accurately than ever before.
Biomedical fund to bridge valley of death
Australia’s new biomedical fund will help to bridge the ‘valleys of death’ and push innovation back into R&D, and bring “billions” in revenue.

Green frontier
Dr Pia Winberg explains how it is possible to improve our gut health by introducing seaweed dietary fibres to the western diet.

Researchers ride new sound wave to health discovery
Acoustics experts have created a new class of sound wave that could lead to a revolution in stem cell therapy.

Safety of chromium questioned
Concerns have been raised over the long-term use of nutritional supplements containing chromium.

Love Hertz
Scientists at JCU have created a cheap and effective audio lure to collect the species of mosquito that carries dengue and yellow fever.

New vision for Indigenous eye care
Innovative toolkit to improve eye care for Indigenous Australia.

Computer vision saves lives
A new automated detection system increases how efficiently we diagnose bacterial infections.

Bioinformatician on the move
Bioinformatician Harriet Dashnow investigates how mutations in the human genome can lead to genetic disorders.

Evaluating Chinese medicine
RMIT researchers have published two reference books on evidence-based clinical Chinese medicine.

Australian researchers develop Big Data tool to test new medicines
Australian scientists have developed a a rapid detection tool to map the effects of new medicines already on the market.

Food recall app
Researchers have developed an innovative app that alerts Australians to recently recalled food products.

Dengue research gets Grand Challenges Explorations grant
The University of Queensland receives Grand Challenges Explorations Grant for groundbreaking research in global health and development.
